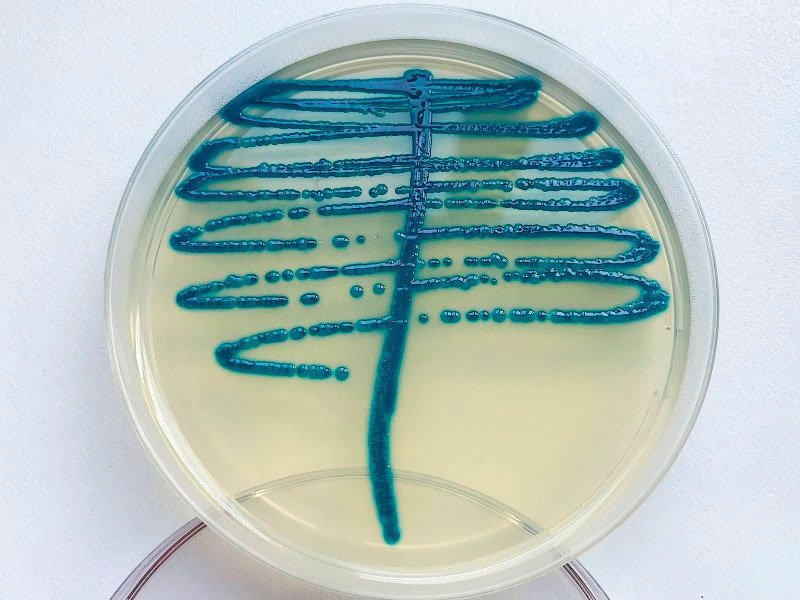

Екатерина Беленко: Промикробы: Ода кишечной микрофлоре
Бактерии Фото: Екатерина Беленко Кишечник — неиссякаемый источник микробиологических знаний, ведь, по прикидкам учёных, в нём содержится в среднем около 50 триллионов микроорганизмов, что примерно в 1,3 раза больше, чем суммарное количество клеток в нашем организме. Не знаю, как вам, а мне до сих пор трудно этот факт осознать. Ведь мы ж такие сложные, с высшей нервной деятельностью, делаем ракеты и перекрыли Енисей. Около 500 различных видов бактерий квартируют в кишечнике, а он не резиновый. Как и другие «понаехавшие», микробики трудятся за еду и жильё. Они помогают переваривать пищу, вырабатывать витамины и даже мешать развитию болезней, вытесняя «злые» бактерии.
⠀
Чем разнообразнее микробная рабочая сила, тем большее количество задач она выполняет, а это нам на пользу. Одна из таких задач — расщепление пищевых волокон из растительной пищи, которые нашим человеческим ферментам не по зубам. Представляете, кишечная микрофлора даже умеет адаптироваться к изменениям режима питания, например, к сезонности употребления тех или иных продуктов. Кроме того, состав кишечных квартирантов различается у представителей разных стран и культур. Например, у японцев есть микробы, расщепляющие полисахариды водорослей. А у меня наверняка есть микробы, расщепляющие полисахариды окрошки (на квасе).
⠀
Из всего разнообразия кишечных микроорганизмов я хочу сегодня остановиться на клебсиелле. Она является представителем нормальной микрофлоры кишечника человека. В то же время клебсиелла может вызывать ряд гастроэнтерологических заболеваний, перейдя на тёмную сторону. Она может начать интенсивно размножаться, вызывая патологический процесс в желудочно-кишечном тракте, например, после терапии антибактериальными препаратами, потому что антибиотики подавляют основных представителей нормальной микрофлоры кишечника, тормозящих чрезмерный рост клебсиелл.
⠀
В норме клебсиелла живёт не только в кишечнике, но и на коже и слизистых. А не в норме вызывает урогенитальные инфекции, конъюнктивиты, менингиты, сепсис. Очень разносторонняя личность. Бороться с клебсиеллой можно антибиотиками, но не любыми — к очень многим она уже выработала механизмы устойчивости, то есть надо ещё поискать, чем её убить. В феврале 2017 года ВОЗ причислила клебсиеллы к наиболее опасным бактериям в связи с их резистентностью к существующим антибактериальным препаратам. Так что не злите своих клебсиелл.
Смотрите также: Екатерина Беленко Промикробы: Грибы большие и маленькие Екатерина Беленко Промикробы: моча, окутанная мифами Екатерина Беленко Промикробы: Загадочный дисбактериоз Екатерина Беленко Промикробы: Знакомьтесь, синегнойная палочка!